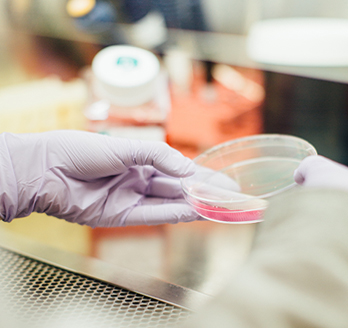

Dean's Message
Historically, human society has gone through different forms of civilization, including primitive civilization, agricultural civilization, and now industrial civilization. Although industrial civilization has created unprecedented material prosperity, its excessive exploitation of nature has destroyed the ...

Introduction to SE
The School of Environment (SE) of Northeast Normal University (NENU) was established and developed basing on its predecessor, the Institute of Environmental Science (1978). After about 40 years of rapid development, SE has received prestigious reputation and worldwide recognition in various research areas. Our mission is to provide...

Academic Exchanges
-
1
-
2
Academic Report: Audio-vocal integration in echolocation bats
January 10, 2018 -
3
-
4
-
5
- View More >>



Milestones
-
Prof. QU Jiuhui, a member of academician of the Chinese Academy of Engineering, was employed as a...
?On March 21, 2017, Prof. QU Jiuhui, academician of the Chinese Academy of Engineering, was employed as a distinguished professor by our university. Meanwhile, Prof. LIU Huijuan and Prof. LIU Ruip...
-
School of Environment was approved as International Demonstration School of Foreign Students
In June 2017, the School of Environment was approved by Northeast Normal University as International Demonstration School for Foreign Students. The school is also the only one to receive this progr...
-
The first foreign students from the countries along “One Belt and One Road” were enrolled in Sc...
In September 2017, the first batch of foreign students from the countries along “One Belt and One Road” were enrolled in School of Environment.